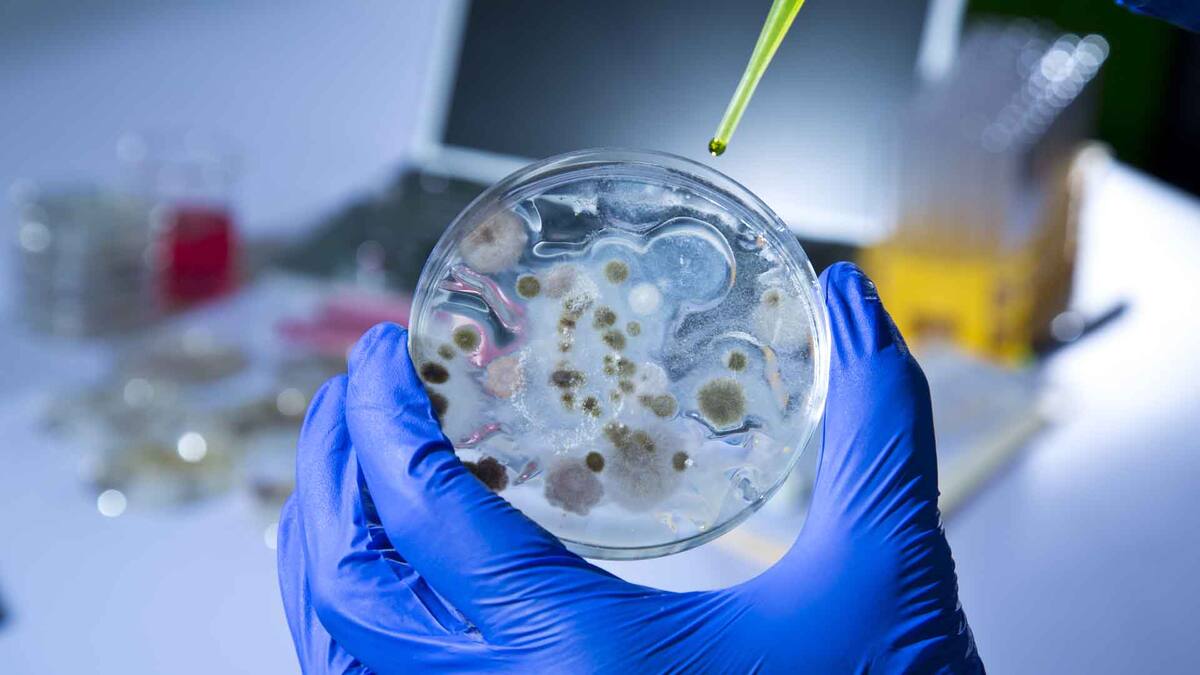

La era de los médicos que recetan a sus pacientes antibióticos poderosos mientras esperan los resultados de laboratorio podría quedar pronto en el pasado, gracias a un nuevo dispositivo que arroja resultados en minutos en lugar de días.
El aparato fue inventado por un equipo de la Universidad Penn State, en Estados Unidos, y descrito en un informe difundido en la publicación de procedimientos de la Academia Nacional de Ciencias esta semana.
Co-desarrollado por Pak Kin Wong, profesor de ingeniería biomédica y mecánica, el dispositivo utiliza microtecnología para atrapar células de bacterias individuales que luego pueden verse bajo un microscopio electrónico.
El enfoque permite a los médicos determinar en tan solo 30 minutos si las bacterias están presentes y su reacción al tratamiento con medicamentos, a diferencia del plazo de tres a cinco días que toma el trabajo de laboratorio.
'Actualmente prescribimos antibióticos aún cuando no hay bacterias presentes', dijo Wong .
'Eso es sobreprescripción. Esa es una de las cosas que tratamos de resolver. ¿Podemos determinar rápidamente la existencia de una infección bacterial?', se preguntó.
Los investigadores dicen en el informe que además de ser capaces de detectar si la bacteria está presente, el dispositivo podría clasificar su tipo, determinando si las células son esféricas, alargadas o espirales.
'Este dispositivo determina la existencia, pero no el tipo de bacteria que es', dijo Wong. 'En lo que estamos trabajando es en un enfoque molecular complementario que nos permita identificar a las especies', agregó.
Luego de hallar la bacteria, la muestra se expone a antibióticos para determinar su resistencia, y en qué casos pueden resultar ineficientes.
'Las infecciones urinarias son las infecciones bacterianas más comunes', explicó.
'Sin embargo, más del 75% de las muestras de orina enviadas a un laboratorio de microbiología clínica son negativas. Descartar o confirmar rápidamente la presencia de bacterias en una concentración clínicamente relevante mejorará de manera drástica la atención al paciente'.
Además, dijo que el equipo había solicitado una patente provisional mientras esperan reducir en tamaño el dispositivo para que pueda ser utilizado en hospitales y consultorios médicos. La expectativa es comercializarlo dentro de tres años.